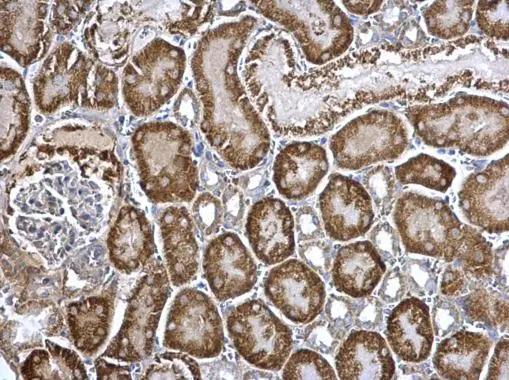
ARG2 antibody detects ARG2 protein at mitochondria on mouse kidney by immunohistochemical analysis. Sample: Paraffin-embedded mouse kidney. ARG2 antibody (GTX118048) dilution: 1:500. 
 Antigen Retrieval: Trilogy? (EDTA based, pH 8.0) buffer, 15min

ARG2 antibody detects ARG2 protein at mitochondria by immunofluorescent analysis. Sample: HepG2 cells were fixed in ice-cold MeOH for 5 min. Green: ARG2 protein stained by ARG2 antibody (GTX118048) diluted at 1:500. Blue: Hoechst 33342 staining.
ARG2 antibody
GTX118048
ApplicationsImmunoFluorescence, Western Blot, ImmunoCytoChemistry, ImmunoHistoChemistry, ImmunoHistoChemistry Paraffin
Product group Antibodies
ReactivityHuman, Mouse, Rat
TargetARG2
Overview
- SupplierGeneTex
- Product NameARG2 antibody
- Delivery Days Customer9
- Application Supplier NoteWB: 1:500-1:3000. ICC/IF: 1:100-1:1000. IHC-P: 1:100-1:1000. *Optimal dilutions/concentrations should be determined by the researcher.Not tested in other applications.
- ApplicationsImmunoFluorescence, Western Blot, ImmunoCytoChemistry, ImmunoHistoChemistry, ImmunoHistoChemistry Paraffin
- CertificationResearch Use Only
- ClonalityPolyclonal
- Concentration1 mg/ml
- ConjugateUnconjugated
- Gene ID384
- Target nameARG2
- Target descriptionarginase 2
- Target synonymsarginase-2, mitochondrial, L-arginine amidinohydrolase, L-arginine ureahydrolase, arginase II, arginase, type II, kidney arginase, kidney-type arginase, non-hepatic arginase, nonhepatic arginase, type II arginase
- HostRabbit
- IsotypeIgG
- Protein IDP78540
- Protein NameArginase-2, mitochondrial
- Scientific DescriptionArginase catalyzes the hydrolysis of arginine to ornithine and urea. At least two isoforms of mammalian arginase exists (types I and II) which differ in their tissue distribution, subcellular localization, immunologic crossreactivity and physiologic function. The type II isoform encoded by this gene, is located in the mitochondria and expressed in extra-hepatic tissues, especially kidney. The physiologic role of this isoform is poorly understood; it is thought to play a role in nitric oxide and polyamine metabolism. Transcript variants of the type II gene resulting from the use of alternative polyadenylation sites have been described. [provided by RefSeq]
- ReactivityHuman, Mouse, Rat
- Storage Instruction-20°C or -80°C,2°C to 8°C
- UNSPSC41116161